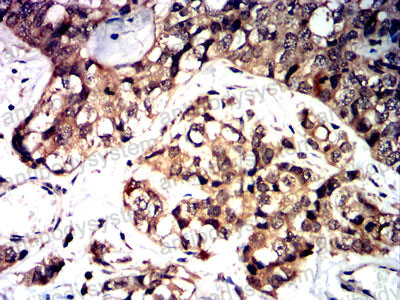
Валидация AntibodySystem RHN14704

| UNIPROT | Q95460 |
Anti-MR1 Antibody (R3Z92) (RHN14704)
Реактивность подтвержденная:
человек
Источник (хозяин):
мышь
Валидировано для:
ELISA
FCM
IF
IHC
Характеристики
Техническое описание
| Русское название | RHN14704 Моноклональное антитело к MR1 (R3Z92) <AntibodySystem,Китай> |
| Каталожный номер | RHN14704 |
| Название антигена | Major Histocompatibility Complex Class I Related Gene Protein (MR1) |
| UNIPROT | Q95460 |
| Английские синонимы | HLALS, Class I histocompatibility antigen-like protein |
Реактивность подтвержденная Нужна другая реактивность? |
человек |
| Источник (хозяин) | мышь |
| Изотип | IgG2a |
| Клональность | моноклональное |
| Клон | R3Z92 |
| Рекомбинантное | да |
| Готовое к использованию | нет |
| Концентрация | 1 мг/мл |
| Конъюгат | нет |
| Валидировано для | ELISA FCM IF IHC Иммуноферментный анализ; Проточная цитометрия; Иммунофлуоресценция; Иммуногистохимия |
| Рекомендуемые разведения | ELISA: 1:10000, FCM: 1:200-1:400, IF: 1:200-1:1000, IHC: 1:200-1:1000 |
| Метод очистки | Очистка с белками A/G из супернатанта клеточной культуры |
| Чистота | >95% |
| Состав буфера | 0.01M PBS, pH 7.4, 0.05% натрия азид |
| Условия хранения | Хранить при 4°C не более 1-2 недель. Хранить при -20°C - 12 месяцев |
| Срок хранения | 12 месяцев |
| Производитель | AntibodySystem |
| Ссылка на страницу товара на сайте производителя | https://www.antibodysystem.com/product/37050.html |
|
Артикул
|
Наименование |
Производитель
|
|---|
|
Артикул
|
Наименование |
Производитель
|
|---|
Акции и предложения
Популярные продукты:
Goat Keratin 10 ELISA kit (E06K0201)
Организм: коза
Rabbit Carnitine Acylcarnitine Translocase ELISA kit (E04C2512)
Организм: кролик
Anti-HCoV-OC43 M/Membrane protein Polyclonal Antibody (PVV40801)
Источник (хозяин): кролик
Реактивность подтвержденная: вирусы
Валидировано для: ELISA, IHC, WB
Реактивность подтвержденная: вирусы
Валидировано для: ELISA, IHC, WB
Anti-DLX1 Antibody (L43/40) (RHF15101)
Источник (хозяин): мышь
Реактивность подтвержденная: для всех
Валидировано для: IHC, WB
Реактивность подтвержденная: для всех
Валидировано для: IHC, WB
Recombinant Human EGLN3 Protein, N-His (YHK56201)
Источник (хозяин): E.coli
Организм: человек
Фрагмент: Met1-Asp239
Теги: N-His
Биоактивность: нет
Организм: человек
Фрагмент: Met1-Asp239
Теги: N-His
Биоактивность: нет